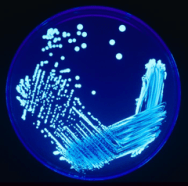
Legionella_Plate_01

Two patients who were admitted to the University of Washington Medical Center (UWMC)’s cardiac unit in late August were subsequently diagnosed with Legionnaires’ disease, a severe form of pneumonia which can be fatal in up to 50% of hospital-acquired cases. While one of these unnamed patients was treated and released, the other patient – a resident of Benton County – has died
Archives
-
Join 346 other subscribers
KSWFoodWorld
Blog Stats
- 444,949 Views